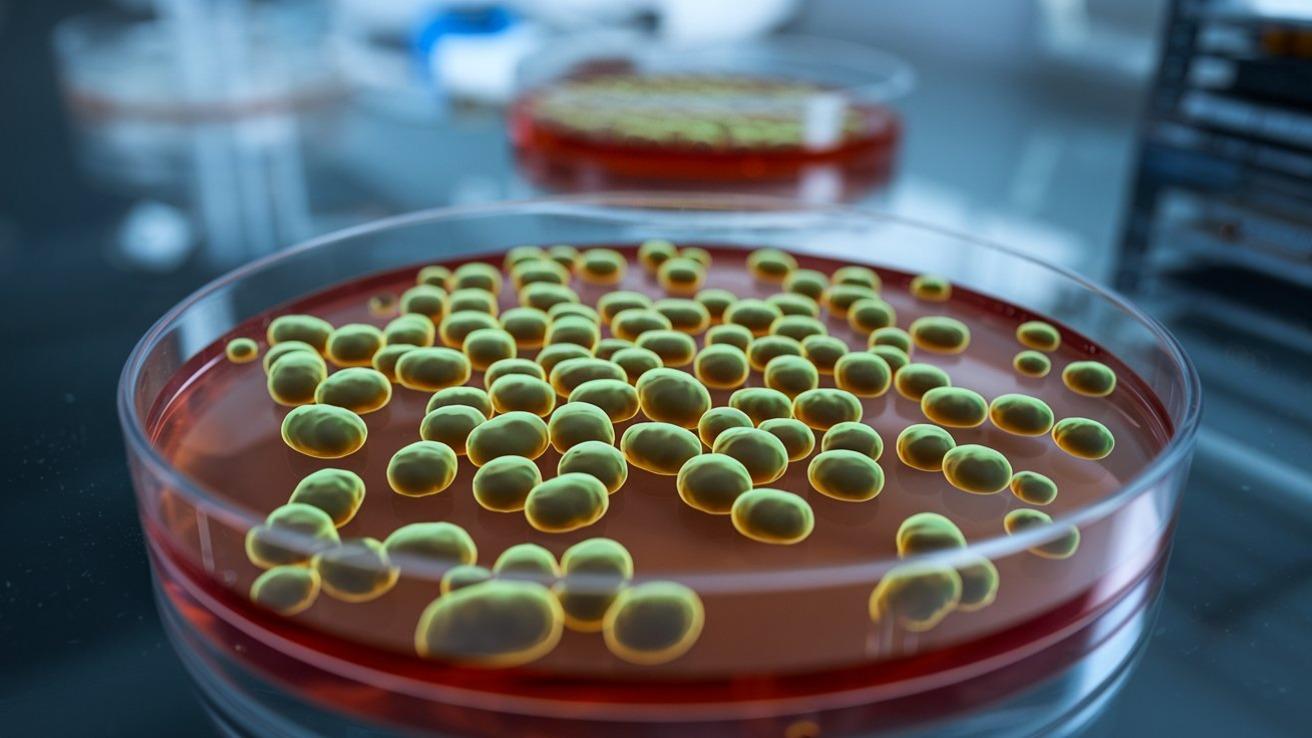
とびひ Q1 - 皮膚科Q＆A 公益社団法人日本皮膚科学会

ブドウ 球菌 皮膚 炎 画像 (367 無料画像)
とびひ ブドウ球菌性写真で見る「子どもの病気」 - みやけ内科・循環器科 総合内科のアプローチ。
101A6ブドウ球菌性熱傷様皮膚症候群 国試テコプラ。
とびひ – 西三河の皮膚科・美容皮膚科あおい皮フ科クリニック肌・美容のお悩みに。
とびひ 伝染性膿痂疹- 板橋区成増駅前かわい皮膚科。
SSSS ブドウ球菌性熱傷様皮膚症候群 野田市 小児科 千葉県 こどもの花粉症 こどもの漢方 喘息 アトピー性皮膚炎 アレルギー 結節性痒疹たんぽぽこどもクリニック。
注意すべき点「とびひ」の治療皮膚科疾患情報とびひ 伝染性膿痂疹 製薬会社のマルホ。
足が赤く腫れて痛い 傷から細菌が侵入「蜂窩織炎」に - 日本経済新聞。
大阪・天王寺の皮膚科なら浜口皮ふ科形成外科天王寺│天王寺駅MIOプラザ館6F。
とびひ ブドウ球菌性写真で見る「子どもの病気」 - みやけ内科・循環器科 総合内科のアプローチ。
とびひ」伝染性膿痂疹 でんせんせいのうかしん について国分寺市の小児科 小森こどもクリニック。
湿疹や水ぶくれが急に増えたら それって「とびひ」かも? とびひは、細菌が皮膚に感染することで発症し、人にうつる病気です。とびひはすり傷や虫刺され、湿疹や汗疹 あせも を掻いてできた傷口に細菌が入り込み、感染することで発症します。 とひびの原因となる細菌は。
ブドウ球菌性熱傷様皮膚症候群 SSSSよく見られる子どもの病気 - みやけ内科・循環器科 家庭の医学。
アトピー性皮膚炎の原因に黄色ブドウ球菌が関与していた?治験・モニター情報の総合掲載サイト:インクロムNAVI。
アトピー性皮膚炎患者の皮膚細菌叢:多様性と競合が織りなす複雑な世界 大塚篤司- エキスパート - Yahoo!ニュース。
とびひ ブドウ球菌性写真で見る「子どもの病気」 - みやけ内科・循環器科 総合内科のアプローチ。
消毒のしすぎ、手荒れに注意ー皮膚の善玉常在菌の表皮ブドウ球菌の役割食品微生物学 検査と制御方法 基礎と最新情報を解説木村 凡。
とびひ ブドウ球菌性写真で見る「子どもの病気」 - みやけ内科・循環器科 総合内科のアプローチ。
黄色ブドウ球菌による伝染性膿痂疹 飛び火・とびひ の治し方」のホームページを作りました。橋本クリニック ゆめタウン呉呉市 皮膚科。
とびひ Q1 - 皮膚科Q&A 公益社団法人日本皮膚科学会。
とびひ ブドウ球菌性写真で見る「子どもの病気」 - みやけ内科・循環器科 総合内科のアプローチ。
とびひ 伝染性膿痂疹とびひ でんせんせいのうかしん家庭の医学時事メディカル時事通信の医療ニュースサイト。
ブドウ球菌性熱傷様皮膚症候群 - 17. 皮膚の病気 - MSDマニュアル家庭版。
アトピー発症の原因 前編アトピー脱ステロイド専門入院自然療法『ナチュラルクリニック21』。
ブドウ球菌性熱傷様皮膚症候群ぶどうきゅうきんせいねっしょうようひふしょうこうぐん とは済生会。
季節の皮膚病 今回は伝染性膿痂疹 いわゆるとびひ と言われるものです 虫刺され 湿疹 些細な傷などの ブドウ球菌などの 細菌が感染して生じます 放置したり ステロイド軟膏を ご使用になると 急速に拡がり ます 露出部に出ると 登校不可になったり 更に悪化すると。
とびひ ブドウ球菌性 写真で見る「子どもの病気」 - みやけ内科・循環器科。
黄色ブドウ球菌による伝染性膿痂疹 飛び火・とびひ の治し方橋本クリニック ゆめタウン呉呉市 皮膚科。
湿疹や水ぶくれが急に増えたら それって「とびひ」かも? とびひは、細菌が皮膚に感染することで発症し、人にうつる病気です。とびひはすり傷や虫刺され、湿疹や汗疹 あせも を掻いてできた傷口に細菌が入り込み、感染することで発症します。 とひびの原因となる細菌は。
ブドウ球菌性熱傷様皮膚症候群 SSSSStaphylococcal scalded skin syndrome– 感染症 -神戸きしだクリニック 神戸市中央区。
アトピー発症の原因 前編アトピー脱ステロイド専門入院自然療法『ナチュラルクリニック21』。
練馬区でとびひの治療ならサマンサクリニックおすすめ皮膚科。
毛嚢炎 毛包炎 の原因 症状・疾患ナビ健康サイト。
ブドウ球菌性熱傷様皮膚症候群 - 医師国家試験対策wiki - atwiki アットウィキ。
114D24ブドウ球菌性熱傷様皮膚症候群 国試テコプラ。
とびひ ブドウ球菌性写真で見る「子どもの病気」 - みやけ内科・循環器科 総合内科のアプローチ。
ブドウ球菌が繁殖!?生後2週間で出たひどい乳児湿疹エピソードベビーカレンダ。
18208380ブドウ球菌性熱傷様皮膚症候群 CBTテコプラ。
とびひ 伝染性膿痂疹- 板橋区成増駅前かわい皮膚科。
際限のない「湿疹のかゆみ」のメカニズムを解明!炎症ではなく黄色ブドウ球菌が原因 - ナゾロジ。
とびひ ブドウ球菌性写真で見る「子どもの病気」 - みやけ内科・循環器科 総合内科のアプローチ。
とびひ Q13 - 皮膚科Q&A 公益社団法人日本皮膚科学会。
注意すべき点「とびひ」の治療皮膚科疾患情報とびひ 伝染性膿痂疹 製薬会社のマルホ。